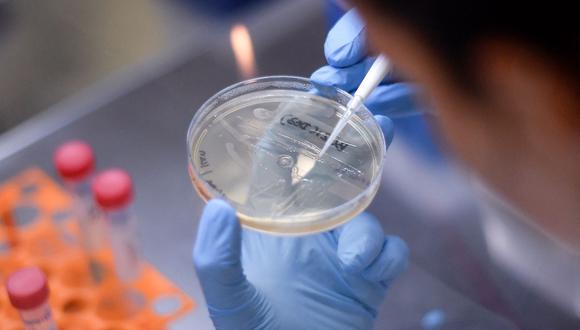

Este jueves 25 de noviembre el ministerio de salud sudafricano dio a conocer al mundo el descubrimiento de una nueva variante del coronavirus. Se trata de la variante B.1.1.529 la cual ha sido clasificada como “muy preocupante” por los expertos producto de su alto grado de evasión inmune y su transmisibilidad mejorada, situación que tiene a la comunidad científica y a la humanidad en alerta.
Según explicó el doctor Tom Peacock, virólogo del Imperial College de Londres en su cuenta oficial de Twitter, esta nueva variante descubierta en el país africano tiene un total de 32 mutaciones en la proteína de pico o proteína ‘spike’, la cual corresponde a la parte del patógeno que utilizan la mayoría de las vacunas para preparar al sistema inmunológico que combate la enfermedad.
Por su alto número de mutaciones, está el riesgo de que la variante pueda potencialmente afectar la capacidad del virus para infectar células y propagarse, pero también podría provocar que las células de defensa de nuestro organismo tengan problemas para atacarlo.
“La cantidad increíblemente alta de mutaciones sugiere que podría suponer una preocupación real”, expuso el científico en un análisis que publicó en su web y en su perfil de Twitter.
Cabe destacar que esta última versión del covid-19 es la más mutada descubierta hasta ahora, es por esto que diferentes científicos de todo el mundo catalogaron a esta variante como ”la peor que habían visto desde el inicio de la pandemia”. Contando con más del doble de mutaciones en relación a la variante Delta y posee también las mutaciones K417N y E484A, que son parecidas a las de la variante Beta que la hicieron más resistente a las vacunas.
Por otro lado, en una convocatoria de emergencia llevada a cabo hoy viernes 26 de noviembre por la OMS, declararon que esta nueva mutación es una “variante de mucha preocupación” ya que la evidencia preliminar sugiere un mayor riesgo de reinfección, bautizándola con el nombre de Ómicron, siendo ya identificada en África, Asia y Europa, en países como Bostwana, Hong Kong, Israel y Bélgica, donde en este último, se halló el primer caso durante la jornada de hoy.
MEDIDAS DE PRECAUCIÓN DE OTROS PAÍSES
Estados Unidos informó que, a partir del lunes 29 de noviembre, se suspenderá la entrada de viajeros extranjeros desde Sudáfrica, Botsuana, Zimbabue, Namibia, Lesoto, Esuatini (Suazilandia), Mozambique y Malaui.
Por su parte, autoridades del Reino Unido también decidieron tomar sus resguardos y los viajeros procedentes de esos mismos países que estén ya en su territorio deberán hacer cuarentena obligatoria, y a contar de este viernes la llegada de viajeros con ese origen quedará restringida.
Francia en su caso, suspendió los vuelos desde estos destinos, además de Suazilandia, con efecto inmediato y durante al menos 48 horas. Alemania, Japón, Italia y Singapur también impusieron restricciones similares.
Asimismo, la Comisión Europea recomendó a los países miembros de la organización impartir un “freno de emergencia” a todos los viajes desde el sur de África.
Esta incertidumbre ha provocado una caída de los precios de las acciones en varios mercados. En los asiáticos, el índice Nikkei de Tokio y el Hang Seng en Hong Kong cayeron más del 2%, viéndose más afectadas aún las acciones en negocios relacionados con viajes.